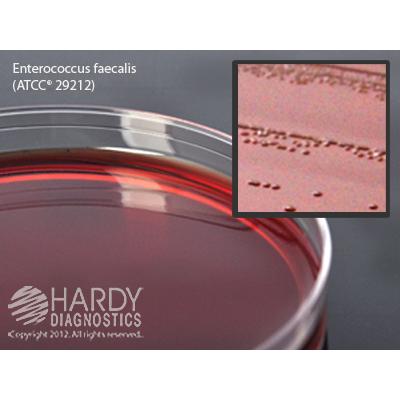

EMB Levine Agar (Eosin Methylene Blue), for culture of gram negative bacteria, 15x100mm plate, Hardy Diagnostics
$22
Image | SKU | Description | Quantity | Price | Add to Cart |
---|---|---|---|---|---|
![]() |
G25 | EMB Levine Agar (Eosin Methylene Blue), for gram negative bacteria, 15x100mm plate | 10 Pack | $22 |
Description
(Eosin Methylene Blue Agar, Levine) For isolation and differentiation of gram negative bacilli. Lactose fermenting gram negative colonies will have dark centers. Non-lactose fermentors will be pink or colorless. Some strains of E. coli, but not all, will produce a "green sheen" on this medium. Most Candida spp will grow on EMB.
Features and Benefits
- Optically clear polystyrene
- For distortion free viewing.
- Heavy-Duty
- Reduces breakage during shipping.
- Stacking rings
- Polystyrene Petri plates feature raised rings for stacking ability and prevents sliding.
- Breathable Packaging
- Packaged in sleeves of 10 plates in a "breathable" bag that prevents buildup of condensation and excess moisture.